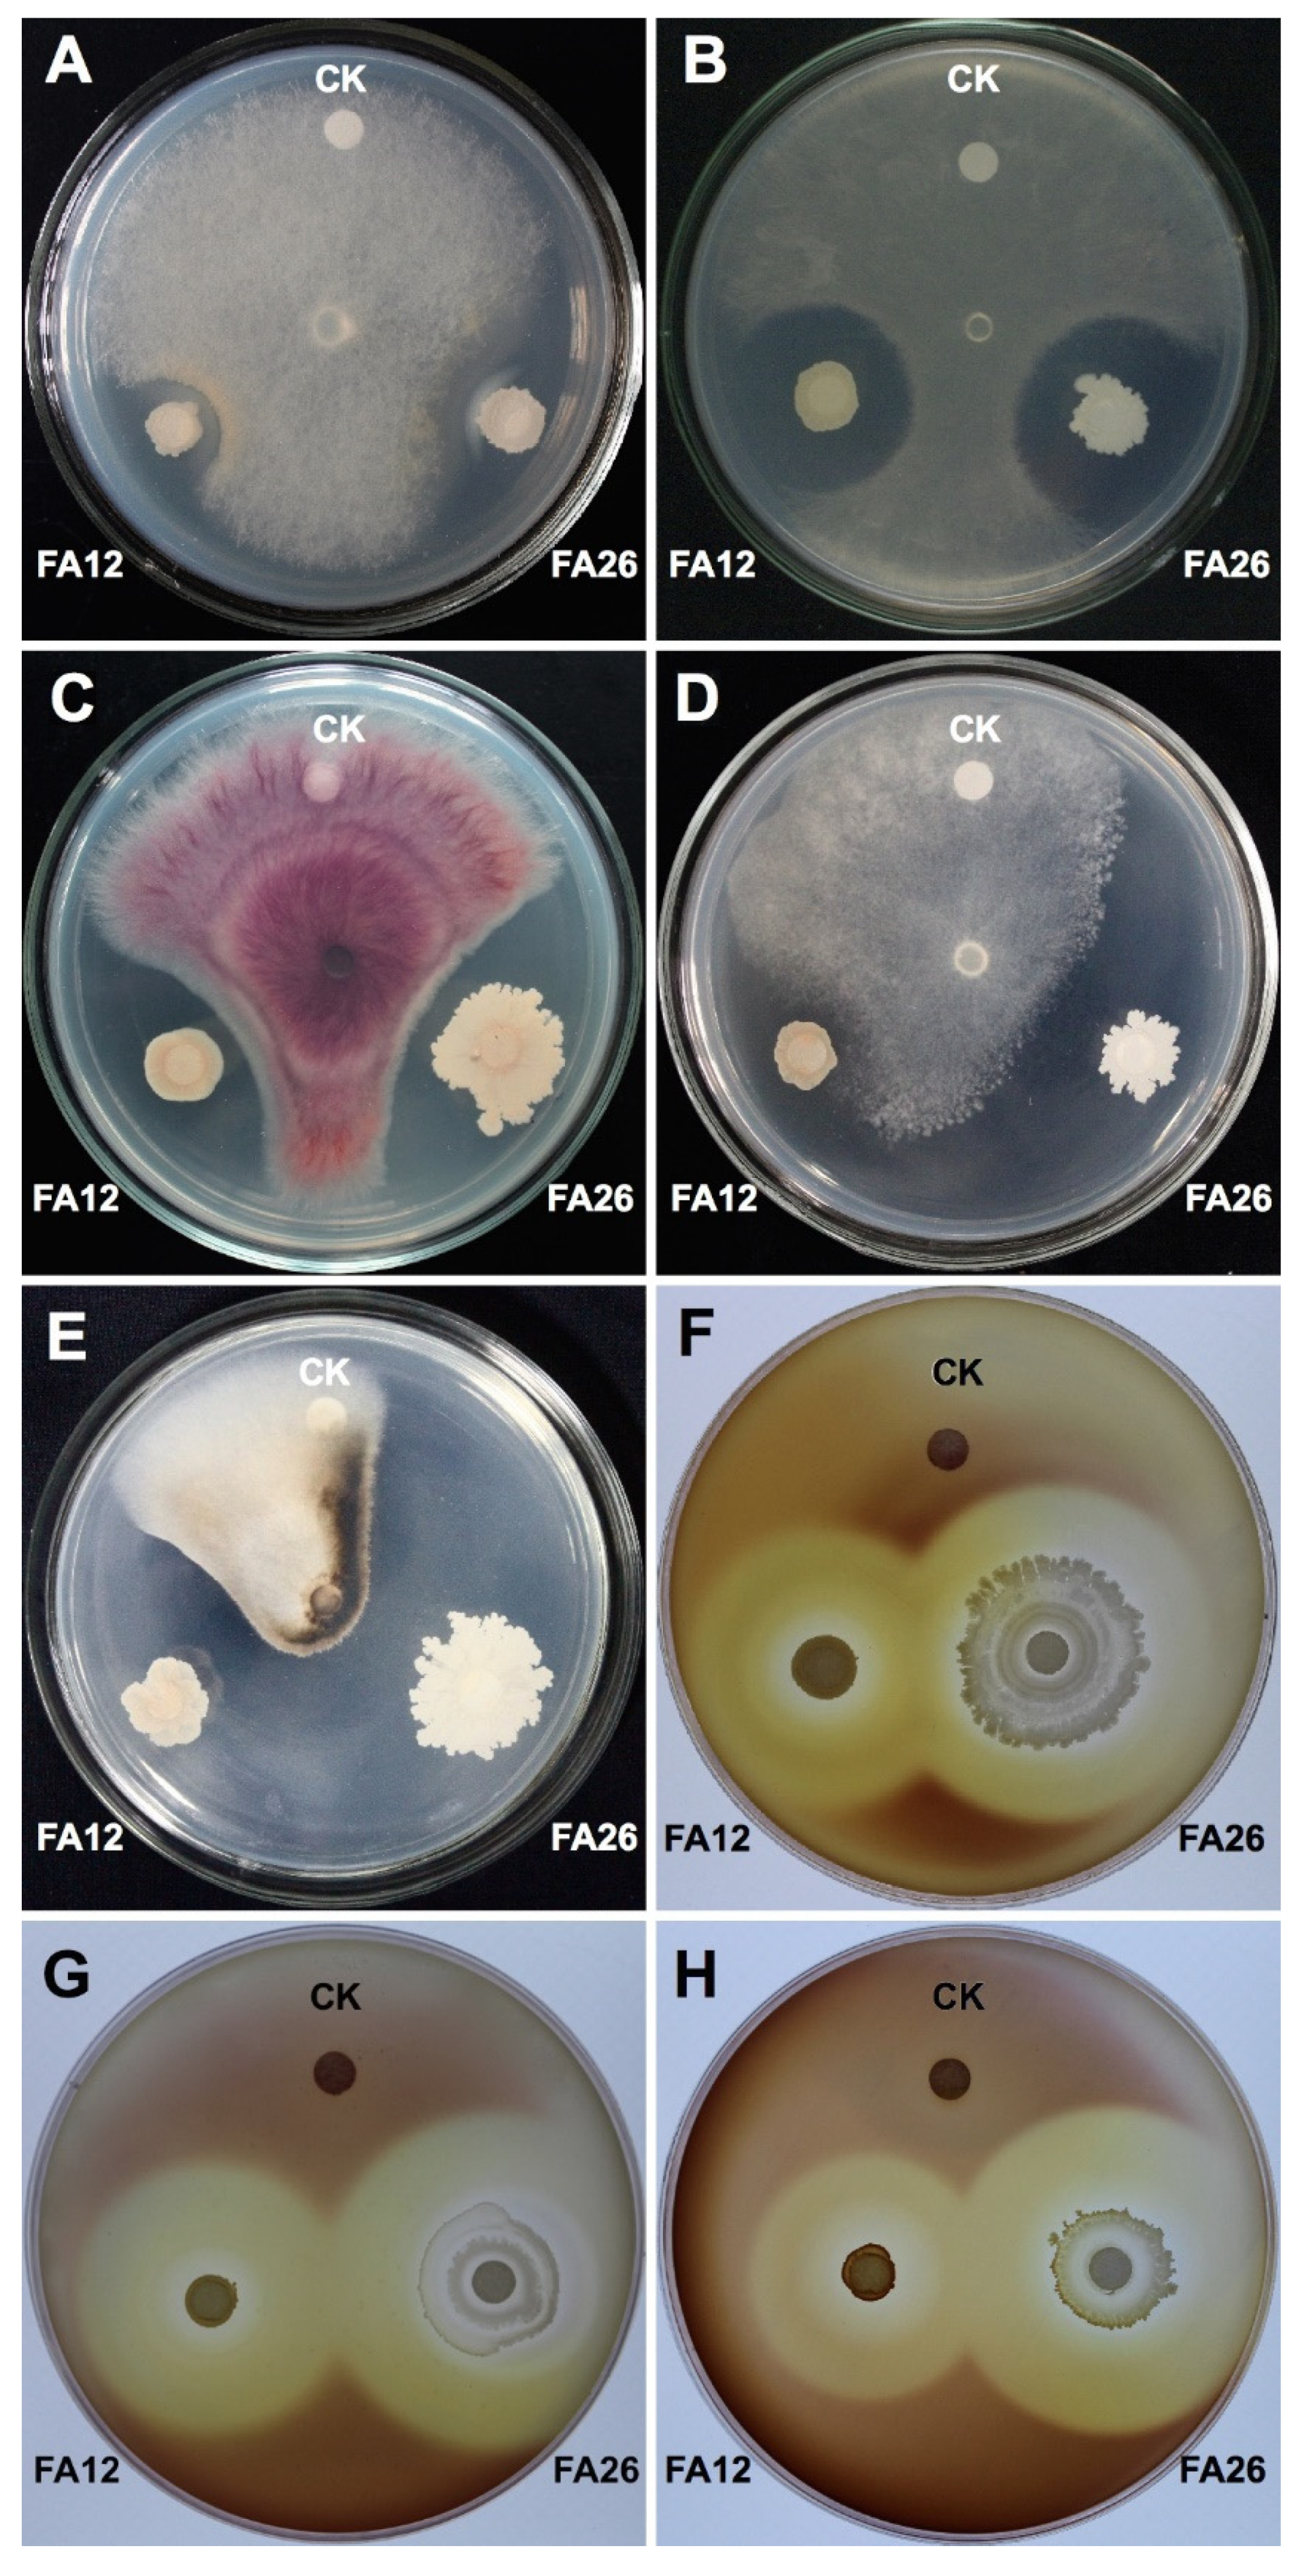

Bacillus spp.-Mediated Growth Promotion of Rice Seedlings and Suppression of Bacterial Blight Disease under Greenhouse Conditions
Abstract
1. Introduction
2. Materials and Methods
2.1. Bacillus Strains and Their Growth Conditions
2.2. Phytopathogens Used in the Study
2.3. In Vitro Antagonistic Activity of Bacillus Strains against Bacterial and Fungal Phytopathogens
2.4. Identification of Potential Antagonists
2.5. Effect of Bacillus spp. on the Growth of Rice Seedlings
2.6. Suppression of BB of Rice by Potential Bacillus spp.
BB Inoculation and Evaluation
2.7. Bacillus Strains Colonization of Rice Roots
2.8. Analysis of Lipopeptides by MALDI-TOF MS
2.9. Data Analysis
3. Results and Discussion
3.1. In Vitro Broad-Range Antagonistic Activity of Bacillus Strains
3.2. Identification of Potential Antagonists
3.3. Growth Promotion of Rice Seedlings by Potential Bacillus spp.
3.4. Suppression of BB Disease by Potential Bacillus spp. under Greenhouse Conditions
3.5. Colonization of FZB42, FA12, and FA26 on Rice Roots
3.6. Identification of Antimicrobial Lipopeptides from Bacillus spp.
4. Conclusions
Author Contributions
Funding
Institutional Review Board Statement
Informed Consent Statement
Data Availability Statement
Conflicts of Interest
References
- Yang, J.; Liu, H.; Zhu, G.; Pan, Y.; Xu, L.; Guo, J. Diversity analysis of antagonists from rice-associated bacteria and their application in biocontrol of rice diseases. J. Appl. Microbiol. 2008, 104, 91–104. [Google Scholar] [CrossRef]
- Wu, X.; Fan, Y.; Wang, R.; Zhao, Q.; Ali, Q.; Wu, H.; Gu, Q.; Borriss, R.; Xie, Y.; Gao, X. Bacillus halotolerans KKD1 induces physiological, metabolic and molecular reprogramming in wheat under saline condition. Front. Plant Sci. 2022, 13, 978066. [Google Scholar] [CrossRef]
- Ali, Q.; Zheng, H.; Rao, M.J.; Ali, M.; Hussain, A.; Saleem, M.H.; Nehela, Y.; Sohail, M.A.; Ahmed, A.M.; Kubar, K.A. Advances, limitations, and prospects of biosensing technology for detecting phytopathogenic bacteria. Chemosphere 2022, 296, 133773. [Google Scholar] [CrossRef]
- Kong, M.; Liang, J.; Ali, Q.; Wen, W.; Wu, H.; Gao, X.; Gu, Q. 5-methoxyindole, a chemical homolog of melatonin, adversely affects the phytopathogenic fungus Fusarium graminearum. Int. J. Mol. Sci. 2021, 22, 10991. [Google Scholar]
- Ali, Q.; Ayaz, M.; Yu, C.; Wang, Y.; Gu, Q.; Wu, H.; Gao, X. Cadmium tolerant microbial strains possess different mechanisms for cadmium biosorption and immobilization in rice seedlings. Chemosphere 2022, 303, 135206. [Google Scholar] [CrossRef]
- Naqvi, S.A.H. Bacterial leaf blight of rice: An overview of epidemiology and management with special reference to Indian sub-continent. Pakistan J. Agric. Res. 2019, 32, 359. [Google Scholar] [CrossRef]
- Ji, G.H.; Wei, L.F.; He, Y.Q.; Wu, Y.P.; Bai, X.H. Biological control of rice bacterial blight by Lysobacter antibioticus strain 13-1. Biol. Control 2008, 45, 288–296. [Google Scholar] [CrossRef]
- Suh, J.-P.; Jeung, J.-U.; Noh, T.-H.; Cho, Y.-C.; Park, S.-H.; Park, H.-S.; Shin, M.-S.; Kim, C.-K.; Jena, K.K. Development of breeding lines with three pyramided resistance genes that confer broad-spectrum bacterial blight resistance and their molecular analysis in rice. Rice 2013, 6, 5. [Google Scholar] [CrossRef]
- Liang, Z.; Ali, Q.; Wang, Y.; Mu, G.; Kan, X.; Ren, Y.; Manghwar, H.; Gu, Q.; Wu, H.; Gao, X. Toxicity of Bacillus thuringiensis strains derived from the novel crystal protein cry31aa with high nematicidal activity against rice parasitic nematode Aphelenchoides besseyi. Int. J. Mol. Sci. 2022, 23, 8189. [Google Scholar] [CrossRef]
- Yu, C.; Liu, X.; Zhang, X.; Zhang, M.; Gu, Y.; Ali, Q.; Mohamed, M.S.R.; Xu, J.; Shi, J.; Gao, X. Mycosubtilin produced by Bacillus subtilis ATCC6633 inhibits growth and mycotoxin biosynthesis of Fusarium graminearum and Fusarium verticillioides. Toxins 2021, 13, 791. [Google Scholar] [CrossRef]
- Gu, Q.; Qiao, J.; Wang, R.; Lu, J.; Wang, Z.; Li, P.; Zhang, L.; Ali, Q.; Khan, A.R.; Gao, X. The role of pyoluteorin from Pseudomonas protegens Pf-5 in suppressing the growth and pathogenicity of Pantoea ananatis on maize. Int. J. Mol. Sci. 2022, 23, 6431. [Google Scholar] [CrossRef]
- Ayaz, M.; Ali, Q.; Farzand, A.; Khan, A.R.; Ling, H.; Gao, X. Nematicidal volatiles from Bacillus atrophaeus GBSC56 promote growth and stimulate induced systemic resistance in tomato against Meloidogyne incognita. Int. J. Mol. Sci. 2021, 22, 5049. [Google Scholar] [CrossRef]
- Krishnamurthy, K.; Gnanamanickam, S.S. Biological control of rice blast by Pseudomonas fluorescens strain Pf7-14: Evaluation of a marker gene and formulations. Biol. Control 1998, 13, 158–165. [Google Scholar] [CrossRef]
- Kumar, P.; Dubey, R.C.; Maheshwari, D.K. Bacillus strains isolated from rhizosphere showed plant growth promoting and antagonistic activity against phytopathogens. Microbiol. Res. 2012, 167, 493–499. [Google Scholar] [CrossRef]
- Ryu, C.-M.; Farag, M.; Hu, C.-H.; Reddy, M.S.; Wei, H.-X.; Paré, P.W.; Kloepper, J.W. Bacterial volatiles promote growth in arabidopsis. Proc. Natl. Acad. Sci. USA 2003, 100, 4927–4932. [Google Scholar] [CrossRef]
- Idris, E.E.; Bochow, H.; Ross, H.; Borriss, R. Use of Bacillus subtilis as biocontrol agent. VI. Phytohormone-like action of culture filtrates prepared from plant growth-promoting Bacillus amyloliquefaciens FZB24, FZB42, FZB45 and Bacillus subtilis FZB37. J. Plant. Dis. Prot. 2004, 111, 583–597. [Google Scholar]
- Kloepper, J.W.; Reddy, M.S.; Rodríguez-Kabana, R.; Kenney, D.S.; Kokalis-Burelle, N.; Martinez-Ochoa, N.; Vavrina, C.S. Application for rhizobacteria in transplant production and yield enhancement. Acta Hortic. 2004, 631, 217–229. [Google Scholar] [CrossRef]
- Idriss, E.E.; Makarewicz, O.; Farouk, A.; Rosner, K.; Greiner, R.; Bochow, H.; Richter, T.; Borriss, R. Extracellular phytase activity of Bacillus amyloliquefaciens FZB45 contributes to its plant-growth-promoting effect. Microbiology 2002, 148, 2097–2109. [Google Scholar] [CrossRef]
- Xie, S.S.; Wu, H.J.; Zang, H.Y.; Wu, L.M.; Zhu, Q.Q.; Gao, X.W. Plant growth promotion by spermidine-producing Bacillus subtilis OKB105. Mol. Plant-Microbe Interact. 2014, 27, 655–663. [Google Scholar] [CrossRef]
- Zasloff, M. Antimicrobial peptides of multicellular organisms. Nature 2002, 415, 389–395. [Google Scholar] [CrossRef]
- Saravanakumar, D.; Vijayakumar, C.; Kumar, N.; Samiyappan, R. PGPR-induced defense responses in the tea plant against blister blight disease. Crop. Prot. 2007, 26, 556–565. [Google Scholar] [CrossRef]
- Kloepper, J.W.; Ryu, C.-M.; Zhang, S. Induced systemic resistance and promotion of plant growth by Bacillus spp. Phytopathology 2004, 94, 1259–1266. [Google Scholar] [CrossRef]
- Ongena, M.; Duby, F.; Jourdan, E.; Beaudry, T.; Jadin, V.; Dommes, J.; Thonart, P. Bacillus subtilis M4 decreases plant susceptibility towards fungal pathogens by increasing host resistance associated with differential gene expression. Appl. Microbiol. Biotechnol. 2005, 67, 692–698. [Google Scholar] [CrossRef]
- Dean, R.; Kan, J.A.N.A.L.V.A.N.; Pretorius, Z.A.; Hammond-kosack, K.I.M.E.; Pietro, A.D.I.; Spanu, P.D.; Rudd, J.J.; Dickman, M.; Kahmann, R.; Ellis, J.; et al. The top 10 fungal pathogens in molecular plant pathology. Mol. Plant Pathol. 2012, 13, 414–430. [Google Scholar] [CrossRef]
- Mansfield, J.; Genin, S.; Magori, S.; Citovsky, V.; Sriariyanum, M.; Ronald, P.; Dow, M.A.X.; Verdier, V.; Beer, S.V.; Machado, M.A.; et al. Top 10 plant pathogenic bacteria in molecular plant pathology. Mol. Plant Pathol. 2012, 13, 614–629. [Google Scholar] [CrossRef]
- Xue, Q.-Y.; Chen, Y.; Li, S.-M.; Chen, L.-F.; Ding, G.-C.; Guo, D.-W.; Guo, J.-H. Evaluation of the strains of Acinetobacter and Enterobacter as potential biocontrol agents against ralstonia wilt of tomato. Biol. Control 2009, 48, 252–258. [Google Scholar] [CrossRef]
- Fajardo-Cavazos, P.; Nicholson, W. Bacillus endospores isolated from granite: Close molecular relationships to globally distributed Bacillus spp. from endolithic and extreme environments. Appl. Environ. Microbiol. 2006, 72, 2856–2863. [Google Scholar] [CrossRef]
- Chen, X.H.; Koumoutsi, A.; Scholz, R.; Schneider, K.; Vater, J.; Süssmuth, R.; Piel, J.; Borriss, R. Genome analysis of Bacillus amyloliquefaciens FZB42 reveals its potential for biocontrol of plant pathogens. J. Biotechnol. 2009, 140, 27–37. [Google Scholar] [CrossRef]
- Asaka, O.; Shoda, M. Biocontrol of Rhizoctonia solani damping-off of tomato with Bacillus subtilis RB14. Appl. Environ. Microbiol. 1996, 62, 4081–4085. [Google Scholar] [CrossRef]
- Zhang, S.; White, T.L.; Martinez, M.C.; McInroy, J.A.; Kloepper, J.W.; Klassen, W. Evaluation of plant growth-promoting rhizobacteria for control of Phytophthora blight on squash under greenhouse conditions. Biol. Control 2010, 53, 129–135. [Google Scholar] [CrossRef]
- Rajer, F.U.; Wu, H.; Xie, Y.; Xie, S.; Raza, W.; Tahir, H.A.S.; Gao, X. Volatile organic compounds produced by a soil-isolate, Bacillus subtilis FA26 induce adverse ultra-structural changes to the cells of Clavibacter michiganensis ssp. sepedonicus, the causal agent of bacterial ring rot of potato. Microbiology 2017, 163, 523–530. [Google Scholar] [CrossRef] [PubMed]
- Berg, G.; Krechel, A.; Ditz, M.; Sikora, R.A.; Ulrich, A.; Hallmann, J. Endophytic and ectophytic potato-associated bacterial communities differ in structure and antagonistic function against plant pathogenic fungi. FEMS Microbiol. Ecol. 2005, 51, 215–229. [Google Scholar] [CrossRef] [PubMed]
- Adesina, M.F.; Lembke, A.; Costa, R.; Speksnijder, A.; Smalla, K. Screening of bacterial isolates from various european soils for in vitro antagonistic activity towards Rhizoctonia solani and Fusarium oxysporum: Site-dependent composition and diversity revealed. Soil Biol. Biochem. 2007, 39, 2818–2828. [Google Scholar] [CrossRef]
- Kasana, R.C.; Salwan, R.; Dhar, H.; Dutt, S.; Gulati, A. A rapid and easy method for the detection of microbial cellulases on agar plates using gram’s iodine. Curr. Microbiol. 2008, 57, 503–507. [Google Scholar] [CrossRef] [PubMed]
- Cho, S.-J.; Lee, S.K.; Cha, B.J.; Kim, Y.H.; Shin, K.-S. Detection and characterization of the Gloeosporium gloeosporioides growth inhibitory compound Iturin A from Bacillus subtilis strain KS03. FEMS Microbiol. Lett. 2003, 223, 47–51. [Google Scholar] [CrossRef]
- Yamamoto, S.; Harayama, S. PCR Amplification and direct sequencing of gyrB genes with universal primers and their application to the detection and taxonomic analysis of Pseudomonas putida strains. Appl. Environ. Microbiol. 1995, 61, 1104–1109. [Google Scholar] [CrossRef]
- Hall, B.G. Building phylogenetic trees from molecular data with MEGA. Mol. Biol. Evol. 2013, 30, 1229–1235. [Google Scholar] [CrossRef]
- Tamura, K.; Peterson, D.; Peterson, N.; Stecher, G.; Nei, M.; Kumar, S. MEGA5: Molecular evolutionary genetics analysis using maximum likelihood, evolutionary distance, and maximum parsimony methods. Mol. Biol. Evol. 2011, 28, 2731–2739. [Google Scholar] [CrossRef]
- Kandasamy, S.; Loganathan, K.; Muthuraj, R.; Duraisamy, S.; Seetharaman, S.; Thiruvengadam, R.; Ponnusamy, B.; Ramasamy, S. Understanding the Molecular basis of plant growth promotional effect of Pseudomonas fluorescens on Rice through protein profiling. Proteome Sci. 2009, 7, 47. [Google Scholar] [CrossRef]
- Wang, W.; Chen, L.-N.; Wu, H.; Zang, H.; Gao, S.; Yang, Y.; Xie, S.; Gao, X. Comparative proteomic analysis of rice seedlings in response to inoculation with Bacillus cereus. Lett. Appl. Microbiol. 2013, 56, 208–215. [Google Scholar] [CrossRef]
- Zhang, M. Procedures for the Wet Paper Towel Germination Test; UAF-Cooperative Ext. Serv. Publ. FGV-00249; University of Alaska Fairbanks: Fairbanks, AK, USA, 2021. [Google Scholar]
- Kauffman, H.E.; Reddy, A.P.K.; Hsieh, S.P.Y.; Merca, S.D. An improved technique for evaluating resistance of rice varieties to Xanthomonas oryzae. Plant Dis. Rep. 1973, 57, 537–541. [Google Scholar]
- Landy, M.; Warren, G.H.; RosenmanM, S.B.; Colio, L.G. Bacillomycin: An antibiotic from Bacillus subtilis active against pathogenic fungi. Proc. Soc. Exp. Biol. Med. 1948, 67, 539–541. [Google Scholar] [CrossRef]
- Liu, J.; Zhou, T.; He, D.; Li, X.; Wu, H.; Liu, W.; Gao, X. Functions of lipopeptides Bacillomycin D and Fengycin in antagonism of Bacillus amyloliquefaciens C06 towards Monilinia fructicola. J. Mol. Microbiol. Biotechnol. 2011, 20, 43–52. [Google Scholar] [CrossRef]
- Leenders, F.; Stein, T.H.; Kablitz, B.; Franke, P.; Vater, J. Rapid typing of Bacillus subtilis strains by their secondary metabolites using matrix-assisted laser desorption/ionization mass spectrometry of intact cells. Rapid Commun. Mass Spectrom. 1999, 13, 943–949. [Google Scholar] [CrossRef]
- Khaskheli, M.A.; Wu, L.; Chen, G.; Chen, L.; Hussain, S.; Song, D.; Liu, S.; Feng, G. Isolation and characterization of root-associated bacterial endophytes and their biocontrol potential against major fungal phytopathogens of rice (Oryza sativa L.). Pathogens 2020, 9, 172. [Google Scholar] [CrossRef]
- Chithrashree; Udayashankar, A.C.; Chandra Nayaka, S.; Reddy, M.S.; Srinivas, C. Plant growth-promoting rhizobacteria mediate induced systemic resistance in rice against bacterial leaf blight caused by Xanthomonas oryzae pv. oryzae. Biol. Control 2011, 59, 114–122. [Google Scholar] [CrossRef]
- Yasmin, S.; Zaka, A.; Imran, A.; Zahid, M.A.; Yousaf, S.; Rasul, G.; Arif, M.; Mirza, M.S. Plant growth promotion and suppression of bacterial leaf blight in rice by inoculated bacteria. PLoS ONE 2016, 11, e0160688. [Google Scholar] [CrossRef]
- Aloo, B.N.; Makumba, B.A.; Mbega, E.R. The potential of Bacilli rhizobacteria for sustainable crop production and environmental sustainability. Microbiol. Res. 2019, 219, 26–39. [Google Scholar] [CrossRef]
- Götz, M.; Gomes, N.C.M.; Dratwinski, A.; Costa, R.; Berg, G.; Peixoto, R.; Mendonça-Hagler, L.; Smalla, K. Survival of gfp-tagged antagonistic bacteria in the rhizosphere of tomato plants and their effects on the indigenous bacterial community. FEMS Microbiol. Ecol. 2006, 56, 207–218. [Google Scholar] [CrossRef]
- Pieterse, C.M.J.; Zamioudis, C.; Berendsen, R.L.; Weller, D.M.; Van Wees, S.C.M.; Bakker, P.A.H.M. Induced systemic resistance by beneficial microbes. Annu. Rev. Phytopathol. 2014, 52, 347–375. [Google Scholar] [CrossRef]
- Lugtenberg, B.; Kamilova, F. Plant-growth-promoting rhizobacteria. Annu. Rev. Microbiol. 2009, 63, 541–556. [Google Scholar] [CrossRef] [PubMed]
- Alijani, Z.; Amini, J.; Ashengroph, M.; Bahramnejad, B.; Mozafari, A.A. Biocontrol of strawberry anthracnose disease caused by Colletotrichum nymphaeae using Bacillus atrophaeus strain DM6120 with multiple mechanisms. Trop. Plant Pathol. 2022, 47, 245–259. [Google Scholar] [CrossRef]
- Chen, C.; Bélanger, R.R.; Benhamou, N.; Paulitz, T.C. Defense enzymes induced in cucumber roots by treatment with plant growth-promoting rhizobacteria (PGPR) and Pythium aphanidermatum. Physiol. Mol. Plant Pathol. 2000, 56, 13–23. [Google Scholar] [CrossRef]
- Elsharkawy, M.M.; Sakran, R.M.; Ahmad, A.A.; Behiry, S.I.; Abdelkhalek, A.; Hassan, M.M.; Khedr, A.A. Induction of systemic resistance against sheath blight in rice by different Pseudomonas isolates. Life 2022, 12, 349. [Google Scholar] [CrossRef] [PubMed]
- De Vleesschauwer, D.; Chernin, L.; Höfte, M.M. Differential effectiveness of Serratia plymuthica IC1270-induced systemic resistance against hemibiotrophic and necrotrophic leaf pathogens in rice. BMC Plant Biol. 2009, 9, 1–16. [Google Scholar] [CrossRef]
- Kamilova, F.; Validov, S.; Azarova, T.; Mulders, I.; Lugtenberg, B. Enrichment for enhanced competitive plant root tip colonizers selects for a new class of biocontrol bacteria. Environ. Microbiol. 2005, 7, 1809–1817. [Google Scholar] [CrossRef]
- Dashti, N.; Prithiviraj, B.; Hynes, R.K.; Smith, D.L. Root and rhizosphere colonization of soybean [Glycine max (L.) Merr.] by plant-growth-promoting rhizobacteria at low root zone temeratures and under short-season conditions. J. Agron. Crop. Sci. 2000, 185, 15–22. [Google Scholar] [CrossRef]
- Pathak, K.V.; Keharia, H. Characterization of fungal antagonistic bacilli isolated from aerial roots of banyan (Ficus benghalensis) using intact-cell MALDI-TOF mass spectrometry (ICMS). J. Appl. Microbiol. 2013, 114, 1300–1310. [Google Scholar] [CrossRef]
- Vater, J.; Gao, X.; Hitzeroth, G.; Wilde, C.; Franke, P. “Whole cell”-matrix-assisted laser desorption ionization-time of flight-mass spectrometry, an emerging technique for efficient screening of biocombinatorial libraries of natural compounds-present state of research. Comb. Chem. High Throughput Screen 2003, 6, 557–567. [Google Scholar] [CrossRef]
- Steller, S.; Vollenbroich, D.; Leenders, F.; Stein, T.; Conrad, B.; Hofemeister, J.; Jacques, P.; Thonart, P.; Vater, J. Structural and functional organization of the fengycin synthetase multienzyme system from Bacillus subtilis B213 and A1/3. Chem. Biol. 1999, 6, 31–41. [Google Scholar] [CrossRef]
- Zeriouh, H.; Romero, D.; Garcia-Gutierrez, L.; Cazorla, F.M.; de Vicente, A.; Perez-Garcia, A. The iturin-like lipopeptides are essential components in the biological control arsenal of Bacillus subtilis against bacterial diseases of cucurbits. Mol. Plant. Microbe. Interact. 2011, 24, 1540–1552. [Google Scholar] [CrossRef]

| Treatments | Germination (%) | Seedling Length (cm) | Vigor Index | Wet Weight (mg) | Dry Weight (mg) | Disease Incidence (%) | Suppression Efficacy (%) | CFU/g Rhizospheric Soil Sample* | ||
|---|---|---|---|---|---|---|---|---|---|---|
| Shoot | Root | Relative Increase (%) | ||||||||
| FZB42 | 95 | 5.7 ± 0.79b | 10.1 ± 1.43a | 1501.0c | 73.73 | 768b | 510b | 10.38 ± 2.76b | 68.44a | (2.2 ± 1.3) × 105a |
| FA12 | 92 | 5.9 ± 0.57b | 10.9 ± 0.74a | 1545.6b | 78.89 | 892a | 617a | 13.24 ± 1.77b | 59.74b | (2.0 ± 0.5) × 105a |
| FA26 | 98 | 6.7 ± 0.26a | 11.7 ± 0.80a | 1803.2a | 108.70 | 834ab | 639a | 14.90 ± 1.38b | 54.70c | (1.7 ± 1.6) × 105a |
| Control | 72 | 4.4 ± 0.20c | 7.6 ± 1.80b | 864.0d | – | 459c | 262c | 32.89 ± 2.14a | – | – |
| Mass Peaks (m/z) | Assignment |
|---|---|
| (1) IturinA (strain: FA12) | |
| 1065.5 1079.5/1095.5 1109.5 | C14-IturinA [M + Na]+ C15-IturinA [M + Na, K]+ C16-IturinA [M + K]+ |
| (2) Fengycin (strains: FA12; FA26) | |
| 1463.9/1485.8 | C14-fengycin [M + H, Na]+ |
| 1477.9/1499.8 | C15-fengycin [M + H, Na]+ |
| 1491.8/1513.8 | C16-fengycin [M + H, Na]+ |
| 1505.8/1529.8 | C17-fengycin [M + H, Na]+ |
Publisher’s Note: MDPI stays neutral with regard to jurisdictional claims in published maps and institutional affiliations. |
© 2022 by the authors. Licensee MDPI, Basel, Switzerland. This article is an open access article distributed under the terms and conditions of the Creative Commons Attribution (CC BY) license (https://creativecommons.org/licenses/by/4.0/).
Share and Cite
Rajer, F.U.; Samma, M.K.; Ali, Q.; Rajar, W.A.; Wu, H.; Raza, W.; Xie, Y.; Tahir, H.A.S.; Gao, X. Bacillus spp.-Mediated Growth Promotion of Rice Seedlings and Suppression of Bacterial Blight Disease under Greenhouse Conditions. Pathogens 2022, 11, 1251. https://doi.org/10.3390/pathogens11111251
Rajer FU, Samma MK, Ali Q, Rajar WA, Wu H, Raza W, Xie Y, Tahir HAS, Gao X. Bacillus spp.-Mediated Growth Promotion of Rice Seedlings and Suppression of Bacterial Blight Disease under Greenhouse Conditions. Pathogens. 2022; 11(11):1251. https://doi.org/10.3390/pathogens11111251
Chicago/Turabian StyleRajer, Faheem Uddin, Muhammad Kaleem Samma, Qurban Ali, Waleed Ahmed Rajar, Huijun Wu, Waseem Raza, Yongli Xie, Hafiz Abdul Samad Tahir, and Xuewen Gao. 2022. "Bacillus spp.-Mediated Growth Promotion of Rice Seedlings and Suppression of Bacterial Blight Disease under Greenhouse Conditions" Pathogens 11, no. 11: 1251. https://doi.org/10.3390/pathogens11111251
APA StyleRajer, F. U., Samma, M. K., Ali, Q., Rajar, W. A., Wu, H., Raza, W., Xie, Y., Tahir, H. A. S., & Gao, X. (2022). Bacillus spp.-Mediated Growth Promotion of Rice Seedlings and Suppression of Bacterial Blight Disease under Greenhouse Conditions. Pathogens, 11(11), 1251. https://doi.org/10.3390/pathogens11111251






